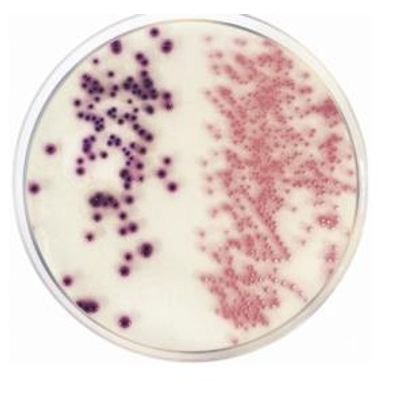

Condalab
Refine by
Families
6 products found
Condalab products
Microbiology - Chromogenic Culture Media
Condalab - Model 2207 - Candida Chromogenic Agar
Differential and selective chromogenic medium for the isolation and quick identification of Candida spp. of clinical importance.
Condalab - Model ISO -2080 - Chromogenic Coliforms Agar (CCA)
Selective medium for the simultaneous detection of E. coli and other coliforms in water samples.
Condalab - Model ISO- 1446 - Chromogenic Cronobacter Isolation Agar (CCI)
For the isolation of presumptive Cronobacter spp. in food products and environmental samples.
Molecular & Cellular Biology - Microbiological Culture Media
Condalab - Model 2xYT -1167 - Microbiological Culture Agar Media
Medium for fibrous bacteriophages.
Condalab - Model 2xYT - 1507 - Microbiological Culture Medium Media
For the cultivation of recombinant strains of E.coli and for growth of filamentous bacteriophages.